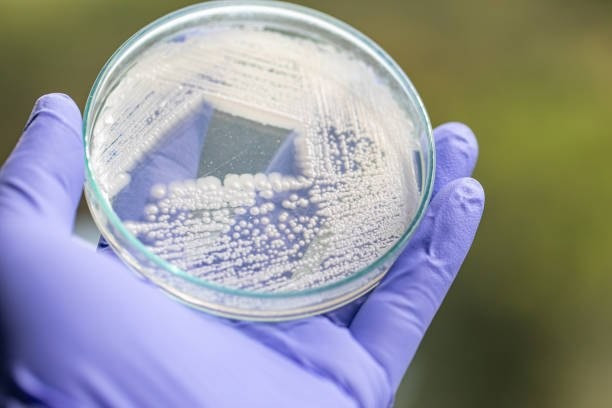
Estonian Startup ÄIO Turns Sawdust into Food-Grade Fat via Precision Fermentation Estonian Startup ÄIO Turns Sawdust into Food-Grade Fat via Precision Fermentation

A biotech startup from Estonia named ÄIO has developed a novel process that converts agricultural waste like sawdust into edible fat using engineered yeast, potentially offering a more sustainable alternative to palm and animal fats. The method, rooted in doctoral research, uses a microbe that consumes sugars derived from lignocellulosic waste and outputs lipids; the resulting fat’s profile closely resembles chicken fat in its solid form and can also be tuned for liquid oil applications. ÄIO has raised roughly $7 million in funding, signed over 100 letters of interest with global firms, and aims to begin commercial-scale production by 2027, with plans to seek regulatory approval in early adopter markets such as Singapore.
Sources: TechBuzz, Green Queen
Key Takeaways
– ÄIO’s fermentation approach could reduce pressure on tropical ecosystems by offering an alternative to palm oil and animal fats, both of which are linked to deforestation and high resource use.
– The startup’s engineered yeast is flexible: it can process agricultural and forestry side‐streams (like wood hydrolysates) and produce fats whose texture, melting point, and stability can be tailored.
– Major challenges remain in scaling the technology, securing regulatory clearances in multiple jurisdictions, and proving cost competitiveness and safety at commercial scale.
In-Depth
In the constant race for sustainable alternatives to ingredients that cause environmental strain, ÄIO’s innovation is striking in its audacity and potential. The company, which spun out of academic research in Estonia, is attempting something few have done at scale: turning agricultural and forestry by-products like sawdust into functional, food-grade fats and oils.
The core of ÄIO’s process is a microbe—essentially a specially engineered yeast—that consumes sugars derived from lignocellulosic biomass. That biomass is first broken down (through pretreatment and enzymatic hydrolysis) to liberate fermentable sugars. The yeast then transforms those sugars into lipids (fats) rather than producing alcohol or carbon dioxide, which is more typical for yeast in baking or brewing. The innovators claim the fat profile it yields is quite similar to existing fats; in its solid state it resembles chicken fat, while by adjusting fermentation parameters they can produce oils akin to canola or other vegetable oils.
What makes this approach compelling is its circularity: it uses waste streams that otherwise have low value, and converts them into high-value ingredients. This has big implications. Palm oil, for example, is ubiquitous across food and cosmetics industries, largely because it is cheap, stable, and versatile. But tropical plantation expansion has come at a hefty environmental cost—deforestation, biodiversity loss, carbon emissions, land conflicts, and more. If a microbial fat can match functionality while cutting those externalities, it could shift supply chains dramatically.
That said, there’s a long road ahead. ÄIO must prove its technology is scalable, efficient, safe, and economically viable. They are targeting a commercial facility by 2027 and are reportedly pursuing regulatory approvals, likely starting in markets more open to novel food sources (Singapore is one such candidate). They have already raised capital (circa $7 million), earned recognition like the Baltic Sustainability Award, and drawn partnerships with more than 100 companies expressing interest. They also secured €6.1 million to build a demonstration facility to scale the fermentation process.
Green Queen’s coverage notes that the funding intends to support a demo facility to turn sawdust into palm oil and animal fat alternatives.
Technically, the field is competitive. Other companies are trying similar approaches—microbial oils from fungi or engineered yeast, precision fermentation of lipids, and blending novel fats into plant-based meats. But ÄIO’s declared strength is in its feedstock flexibility (being able to use lignocellulosic waste streams rather than food crops) and modular fat tuning. The ability to match melting points, oxidative stability, flavor neutrality, and consistency is key in food and cosmetic applications.
From a regulatory perspective, the path is tricky. Every country has its own thresholds for novel food approvals, safety testing, allergen screening, labeling, and food additive classification. Demonstrating consistent purity, absence of toxins or contaminants, and predictable behavior in food matrices will be essential. And from an economic angle, the cost per kilogram of lipid must compete with incumbent fats and oils, factoring in processing and purification costs.
Still, if ÄIO succeeds, the market could change dramatically. The demand for sustainable fats is rising as consumers, brands, and regulators push away from environmental harm. Incorporating such microbial fats could enhance flavor, texture, and shelf stability in plant-based foods, cosmetics, and oleochemical industries. It’s a high-risk, high-reward play: if the company can scale reliably, navigate regulation, and compete on cost, it may help decouple fat production from land-use pressure and contribute to a more resilient, lower-impact supply of lipids for global industry.